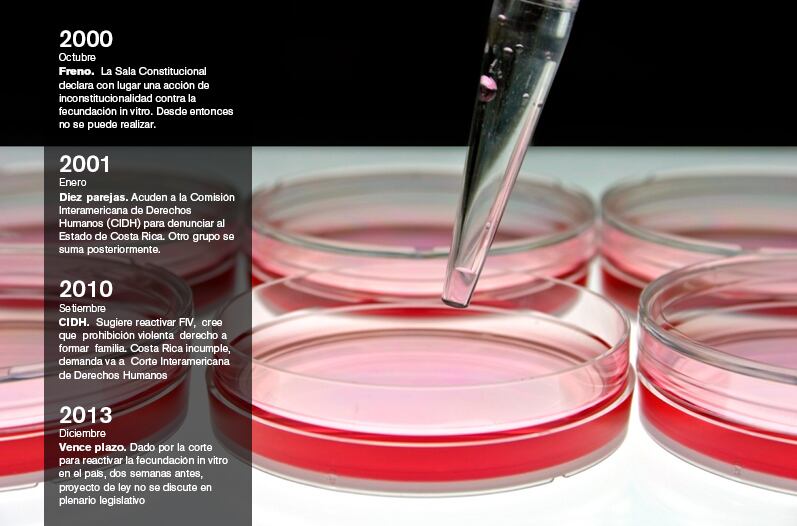

Un año después de emitida la sentencia de la Corte Interamericana de Derechos Humanos (Corte IDH) que obliga a Costa Rica a permitir la fecundación in vitro (FIV), el país sigue sin avanzar en esta materia.
Este 20 de diciembre se cumplirán 365 días desde que la Corte notificó al Estado costarricense su decisión y, entonces, el país deberá presentarle al tribunal un informe sobre el avance que ha hecho para implementar este método de reproducción asistida. Sin embargo, a la fecha no se ha aprobado la ley que regularía el procedimiento.
El proyecto más avanzado fue presentado por el diputado Luis Fishman y aunque ya está en el plenario, no está en discusión.
La tarde de ayer se rechazó una moción para pasarlo del octavo lugar al primer lugar; 33 diputados votaron en contra, por lo que el proyecto debe esperar la discusión de otras siete propuestas.
“Para solventar este problema el proyecto debe estar en primer lugar de discusión. El proyecto de Fishman es escueto, pero ya tiene un texto sustitutivo que define la aplicación de la técnica”, dijo la diputada María Eugenia Venegas, del Partido Acción Ciudadana (PAC).
Boris Molina, abogado de 12 de las parejas que demandaron al Estado para exigir este método reproductivo, afirma que la Corte IDH no especificó sanciones por el rezago.
Sin embargo, aseguró que las sanciones eventuales podrían ir desde multas económicas hasta sanciones morales, como decir que Costa Rica es un país irrespetuoso de los derechos humanos.
La diputada Venegas aseveró que la aprobación de la iniciativa de ley está varada por trabas de varios diputados como Carlos Avendaño, de Restauración Nacional.
“Yo no soy el único diputado que he estado en contra. Vea que 33 diputados votaron en contra de pasar este proyecto a primer lugar, no fui yo solito”, se defendió Avendaño.
Sin recursos. La Caja Costarricense de Seguro Social (CCSS) se prepara para brindar la FIV, sin embargo, no cuenta con el financiamiento, estimado en unos ¢2.000 millones para contar con infraestructura, personal y equipo.
“Hay una química, un médico y un microbiólogo capacitándose en el extranjero. También, cinco ingenieros y arquitectos irán a México para ver la infraestructura”, explicó María Eugenia Villalta, gerente médica de la CCSS.
“Estamos alistando todo para cuando la ley se apruebe brindar el servicio, pero aún estamos en busca de financiamiento”, añadió.
Mientras tanto, el proyecto para regular la FIV sigue esperando y, a partir del 23 de diciembre, esperará 46 días más, hasta que finalice el receso legislativo.
